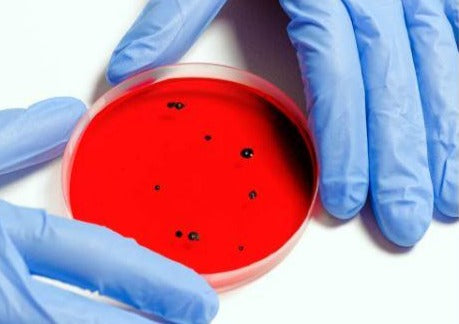

France Vet 2019
Antibiotiques - Ils Ne Seront Plus Jamais Mal Utilisés !
Antibiotiques - Ils Ne Seront Plus Jamais Mal Utilisés !
Couldn't load pickup availability
Synopsis :
Il est malheureusement maintenant courant pour les vétérinaires d’être confrontés à des bactéries multi-résistantes. Dans les dernières décennies, nous avons vu une augmentation du nombre de Staphylocoques résistants à la méthicilline, d’entérobactéries produisant des Bêta-lactamases à spectre étendu,... Afin de limiter le développement de ces résistances, de nouvelles approches et façons d’utiliser les antibiotiques sont nécessaires. « Les antibiotiques ne sont pas automatiques » convient aussi souvent en médecine vétérinaire et certains antibiotiques de deuxième intention ne doivent être utilisés que lorsqu’ils sont clairement justifiés. Il est aussi important de comprendre la pharmacocinétique-pharmacodynamique de ces antibiotiques afin de mieux les utiliser.
Intervenant :
Dr. Julie Lemetayer,
ACVIM, MVSC,
Clinicienne du service de Médecine Interne
CHV Frégis
Please note this session is not RACE-approved but you can still earn a CPD certificate.
Share